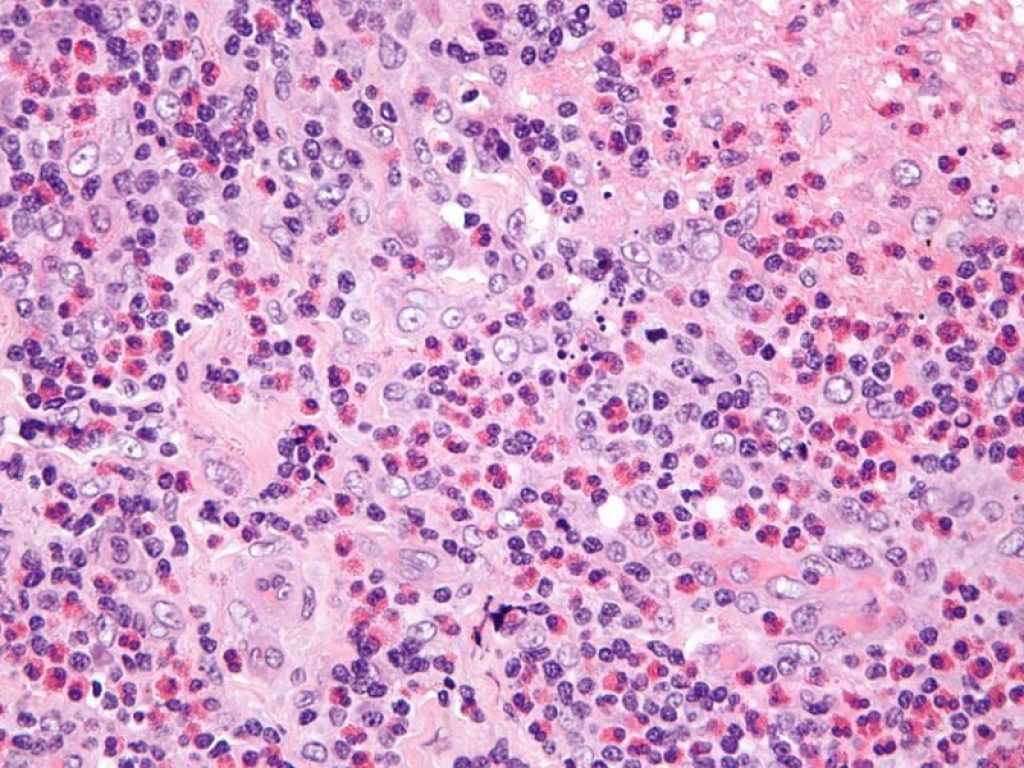
Benralizumab, utilizzato con successo nell'asma grave eosinofilico, è efficace e sicuro anche per la granulomatosi eosinofila con poliangioite

Patologie eosinofile: nasce il Progetto EOS NETWORK 2023 che unisce Associazioni, Società scientifiche, medici e pazienti
Una realtà rara o ultra-rara quella delle patologie eosinofile che richiedono competenze multidisciplinari. Ancora oggi in molte realtà italiane, sono sotto diagnosticate e, cosa ancora più grave, non correttamente inquadrate e curate.
Per questo, le associazioni di pazienti che si occupano di patologie eosinofile hanno deciso di mettere a fattor comune la loro esperienza e le loro competenze per dar vita, per la prima volta in Italia, a un progetto di formazione e informazione completamente dedicato ai pazienti.
“Da molto tempo volevamo realizzare una giornata come questa, che è proprio espressione della struttura della nostra Associazione – dichiara Simona BARBAGLIA, Presidente dell’Associazione Respiriamo Insieme-APS – ossia l’alleanza e la cooperazione tra organizzazioni di pazienti e medici per ottenere i diritti di cura per tutti i pazienti. Unire le forze e le competenze e metterle a disposizione dei pazienti e delle loro famiglie in questo progetto è stata un’esperienza entusiasmante e stimolante che speriamo dia il via a un nuovo modus operandi sempre più collaborativo, propositivo e multidisciplinare nella patient advocacy”.
UNIRE CONOSCENZE E COMPETENZE AL SERVIZIO DEI PAZIENTI
“Le patologie eosinofiliche presentano quadri clinici complessi, difficili da inquadrare e di difficile trattamento che richiedono competenze trasversali da parte dei medici sia per effettuare la diagnosi che per instaurare un adeguato percorso terapeutico. Si tratta di malattie sistemiche multiorgano che, in assenza di una diagnosi precoce e di un adeguato follow-up, possono compromettere in maniera significativa la qualità della vita del paziente. Per questo una presa in carico multidisciplinare e proattiva – spiega Francesca R. TORRACCA, Presidente APACS APS – sono essenziali per una prognosi migliore e una migliore qualità di vita. Siamo molto orgogliosi di essere tra gli organizzatori di questo evento che dimostra come la collaborazione attiva tra le associazioni di pazienti, i medici e le società scientifiche sia fondamentale per dare voce e rappresentanza a pazienti le cui patologie sono invalidanti e poco conosciute”.
“I nostri pazienti spesso arrivano alla diagnosi dopo una lunga odissea di peregrinazioni che costano fisicamente, emotivamente ed economicamente. Desideriamo essere forza propulsiva per coloro che, tra esperti e Istituzioni, hanno la possibilità e la responsabilità di mettere in atto azioni concrete di tutela – continua Roberta GIODICE, Presidente ESEO Italia– e miglioramento della qualità della vita dei malati. La condivisione tra noi famiglie, il confronto, lo scambio di esperienze e la collaborazione con le altre associazioni di pazienti sono una ricchezza che vogliamo alimentare poiché siamo consapevoli dei benefici che da queste alleanze possono avere origine”.
UN NETWORK E UNA GIORNATA CHE NON ESISTEVA
Il progetto EOS NETWORK 2023 è il frutto della collaborazione di 3 associazioni pazienti (Respiriamo Insieme*, APCS* ed ESEO Italia**) che nel corso della giornata dedicata vedrà raccolti importanti specialisti e le persone affette da asma grave eosinofilico, granulomatosi eosinofila con poliangite (EGPA), patologie gastrointestinali eosinofiliche e sindrome ipereosinofila (HES).
Il coordinamento scientifico dell’evento sarà curato da Cristiano CARUSO, Immunologo c/o la Fondazione Policlinico A. Gemelli IRCCS e c/o Fatebenefratelli Gemelli e Vicepresidente della Società Italiana di Allergologia e Immunologia clinica (SIAAIC).
La Società Italiana di Allergologia e Immunologia clinica (SIAAIC), la Società Italiana di Medicina Interna (SIMI) e l’Associazione Allergologi Immunologi Italiani Territoriali e Ospedalieri (AAIITO) hanno dato il patrocinio all’evento.
L’appuntamento è per sabato 29 aprile a Roma dalle 9:00 alle 17:00 c/o NH Hotel Vittorio Veneto, Corso Italia 1 (vedi programma allegato e link)
COSA SONO LE SINDROMI ESINOFILE
Le sindromi eosinofile sono un gruppo di malattie caratterizzate da un’iperproduzione di granulociti eosinofili che si accumulano nei tessuti, provocando la presenza di infiltrati a carico degli organi.
Gli eosinofili sono globuli bianchi (leucociti) chiamati fisiologicamente in causa in presenza di infezioni e infestazioni parassitarie per debellare i germi.
In presenza di patologie eosinofile questo meccanismo si attiva, invece, in maniera patologica e gli eosinofili aggrediscono i tessuti sani degranulando e rilasciando una sostanza tossica, la proteina cationica eosinofila (PCE), che provoca l’infiammazione dei tessuti coinvolti e, in assenza di un tempestivo trattamento terapeutico, il danno d’organo.